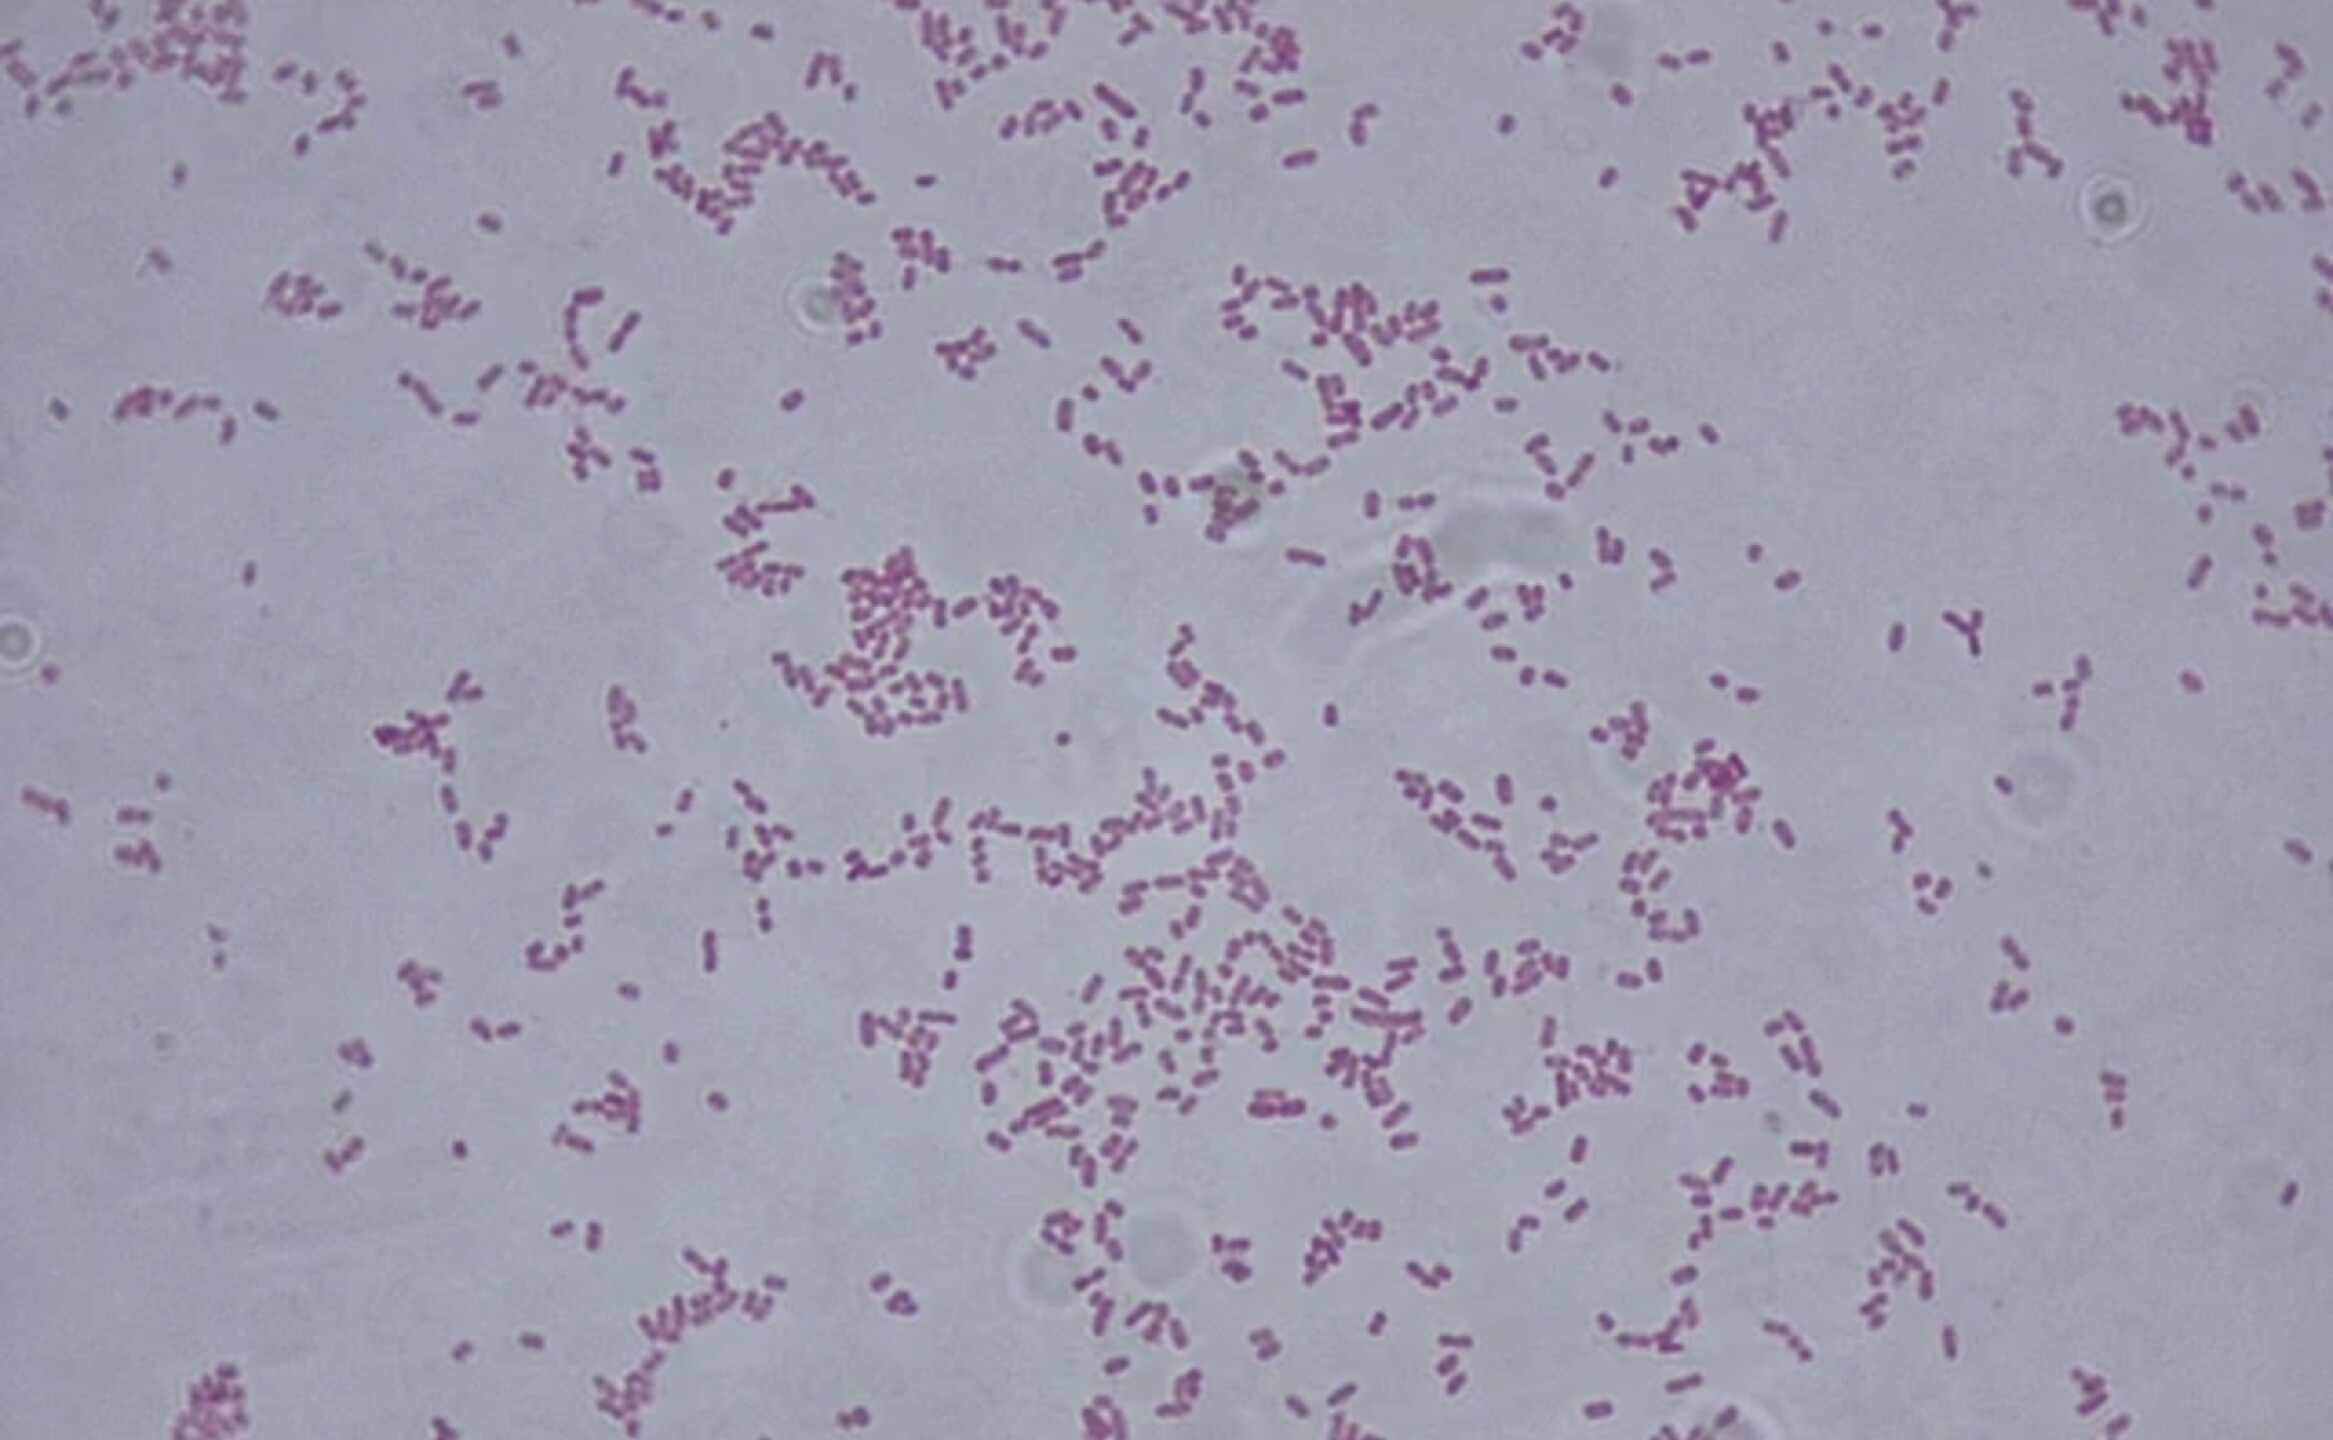
bacteria-Klebsiella_oxytoca

Profeco Emite Alerta por Shampoo Contaminado
28 Ago. 2025
-
La alerta detalla los riesgos para la salud, las posibles reacciones y los lotes del producto que podrían estar afectados
-
Conoce cómo identificar el shampoo y las recomendaciones para proteger a tu familia ante la contaminación detectada
Redacción / CAMBIO 22
La Procuraduría Federal del Consumidor (Profeco) emitió una alerta sanitaria este 26 de agosto, tras identificar que un lote del “Shampoo Totale” podría estar contaminado con la bacteria Klebsiella oxytoca, un microorganismo capaz de provocar infecciones graves en personas con defensas bajas. La institución llamó a la población a suspender de inmediato el uso del producto y revisar las etiquetas para comprobar si corresponden al lote señalado.
De acuerdo con la Profeco, el lote en cuestión presenta riesgo de contaminación debido a fallas en el proceso de producción. Por ello, la dependencia pidió a los consumidores revisar si cuentan en casa con envases de Shampoo Totale, presentación de 750 ml, con lote 23SDU05 y fecha de caducidad de agosto de 2026, ya que es el que podría estar comprometido.
¿Qué es la Klebsiella oxytoca y por qué es peligrosa?
La bacteria Klebsiella oxytoca es un patógeno oportunista, lo que significa que suele afectar principalmente a personas con sistemas inmunológicos debilitados, como pacientes hospitalizados, adultos mayores o quienes padecen enfermedades crónicas. Entre los padecimientos que pueden causar se encuentran:
-
Infecciones urinarias
-
Infecciones gastrointestinales
-
Neumonía
-
Infecciones en heridas o la piel
En casos más graves, puede desencadenar complicaciones si entra al torrente sanguíneo. Aunque no siempre representa un riesgo inmediato para personas sanas, sí se considera una bacteria de cuidado en el ámbito médico.

¿Qué hacer si tienes shampoo contaminado en casa?
La Profeco pidió a la ciudadanía tomar las siguientes medidas de precaución:
-
Verificar la etiqueta del producto: Si corresponde al lote señalado (23SDU05, caducidad agosto 2026), suspende su uso.
-
No intentes “desinfectar” el shampoo por tu cuenta, ya que las bacterias podrían no eliminarse con métodos caseros.
-
Guarde el envase y evite tirarlo a la basura de manera inmediata, ya que podría exponer a otras personas al contaminante.
-
Ponte en contacto con la Profeco a través del Teléfono del Consumidor ( 55 5568 8722 y 800 468 8722) o acude a una delegación cercana para orientación sobre la devolución o reemplazo del producto.
La institución también recordó que el sello de calidad y seguridad sanitaria es responsabilidad de las empresas, por lo que ya se solicitó a la compañía fabricante retirar el lote del mercado e iniciar las acciones correspondientes para evitar más riesgos.

Vigilancia de Profeco en productos de higiene personal
Especialistas en salud explican que este tipo de alertas no son comunes, pero resultan necesarias para garantizar que los productos de uso personal no representan un riesgo. En este caso, se trata de un artículo de higiene diaria, lo que aumenta la probabilidad de contacto directo con la piel, el cuero cabelludo y los ojos.
La Profeco reiteró que seguirá realizando monitoreos aleatorios en distintos productos de cuidado personal. La recomendación general para los consumidores es revisar siempre la caducidad y los números de lote, así como mantenerse atentos a comunicados oficiales.
La alerta sobre el Shampoo Totale contaminado con Klebsiella oxytoca busca proteger la salud de la población antes de que se presenten casos graves. Si cuentas con este producto en casa, lo más recomendable es detener su uso y reportarlo a la Profeco. La prevención y la información son las herramientas más efectivas para cuidar tu bienestar y el de tu familia.
Fuente: La Lista
GPC/MER




















